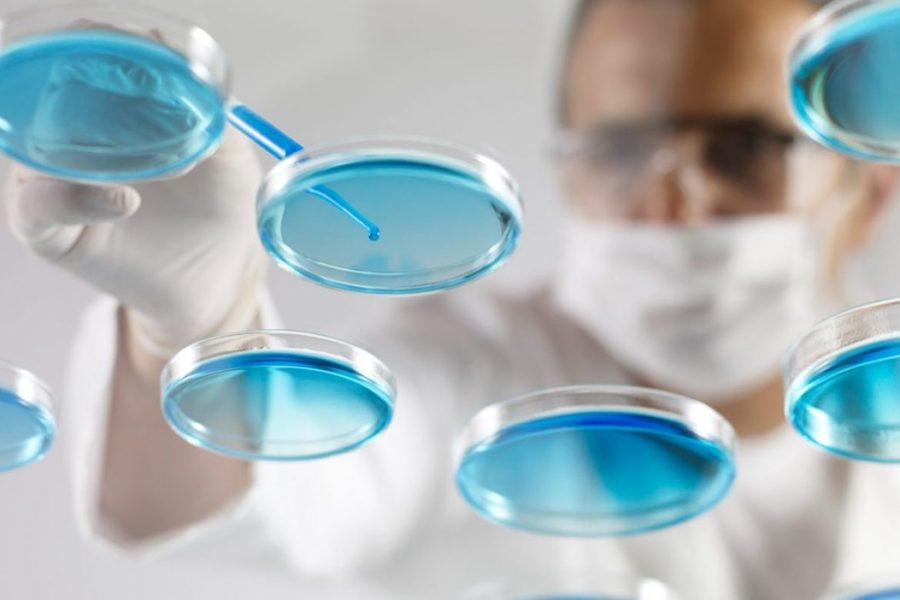

Mambu integrates with Currencycloud for cross border payments
Mambu, a cloud banking platform, and Currencycloud, a global payments platform, have partnered to offer…
Ben (Reactive)09/07/2020